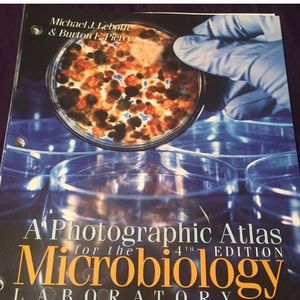
Bundle deal for @jordanhd

MandiG
@msbaker93
London, KY
Sort By:

$13
$50

$8
$30

$18
$35

$28
$50

$10
$30

$13
$45

$22
$60

$5
$20